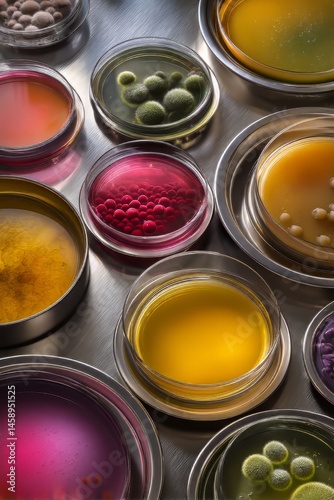

Download sample
File Details
Published: 2025-05-06 13:32:20.637367 Category: Hobbies and Leisure Type: Photo Model release: NoShare
Exploring the Vibrant Spectrum of Colored Liquids in Petri Dishes for Healthcare Solutions
Contributor: J. Thamanoon
ID : 1458951525

